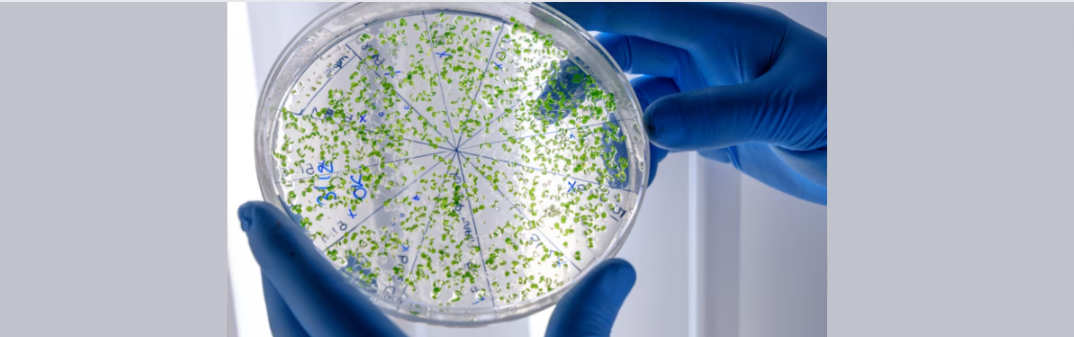
Czym jest mikrobiom skóry?

Czy kąpiel w chlorowanej lub słonej wodzie szkodzi skórze?
Reakcje skórne na chlorowaną lub słoną wodę
Chlor, powszechnie stosowany środek dezynfekcyjny w basenach, ma swoje zalety, ale ze względu na swoje właściwości drażniące dla niektórych osób kontakt z chlorowaną wodą może prowadzić do różnorodnych problemów skórnych. Po kąpieli w chlorowanej wodzie Twoja skóra może stać się sucha, zaczerwieniona i swędząca. Wynika to z uszkodzenia bariery hydrolipidowej skóry, co zwiększa jej podatność na podrażnienia i infekcje. Ponadto chlor może prowadzić do długotrwałych zmian w mikrobiomie skóry, co w konsekwencji osłabia jej naturalną zdolność do ochrony przed szkodliwymi czynnikami zewnętrznymi, pogarszając ogólną kondycję skóry.
Jak objawia się uczulenie na chlor?
W przypadku nadwrażliwości skóry na chlor mogą występować następujące objawy:
- świąd i zaczerwienienie skóry,
- łuszczenie się naskórka.
- podrażnienie i swędzenie spojówek,
- wodnisty katar i kichanie,
- suchość błon śluzowych.
Przeciwskazaniem do kąpieli w chlorowanej wodzie może być atopowe zapalenie skóry. U osób z tym schorzeniem, kontakt z chlorowaną wodą może zaostrzać objawy choroby, powodując intensywniejsze podrażnienia i świąd. Związki chloru w wodzie mogą także wpływać na drogi oddechowe, prowadząc do podrażnień, kaszlu, a w skrajnych przypadkach nawet do świszczącego oddechu i duszności. W skrajnych przypadkach reakcje te mogą być na tyle poważne, że wymagają interwencji medycznej i zastosowania specjalistycznych środków leczniczych, aby zapobiec dalszemu pogarszaniu się stanu zdrowia.
Jak chronić skórę przed negatywnym wpływem chlorowanej lub słonej wody?
Czy to oznacza, że powinniśmy zrezygnować z kąpieli w basenie? Absolutnie nie! Na szczęście istnieje kilka prostych sposobów, które pozwolą Ci ograniczyć negatywny wpływ chlorowanej wody basenowej na skórę. Oto najważniejsze z nich!
Unikaj długich kąpieli
Ograniczenie czasu spędzanego w chlorowanej lub słonej wodzie może znacznie zmniejszyć ryzyko podrażnień. Po kąpieli warto szybko wziąć prysznic, aby zmyć resztki chloru z powierzchni skóry. Dzięki temu ograniczysz czas, w jakim chlor ma kontakt z Twoją skórą, co jest kluczowe w minimalizowaniu podrażnień. Możesz również używać łagodnych mydeł i żeli pod prysznic, które pomogą usunąć chlor bez dodatkowego podrażniania skóry. Dobrym wyborem będzie także olejek do kąpieli i pod prysznic Figa, który zadba o Twoją skórę, pozostawiając ją wypielęgnowaną, czystą i miękką w dotyku.
Stosuj kosmetyki nawilżające
Produkty na bazie emolientów, takie jak te oferowane przez Bielenda, pomagają w odbudowie bariery hydrolipidowej skóry. Aplikacja kremów i balsamów nawilżających i natłuszczających bezpośrednio po kąpieli jest kluczowa. Emolienty tworzą warstwę ochronną na skórze, która zabezpiecza ją przed utratą wilgoci i chroni przed dalszymi uszkodzeniami. Idealnym wyborem na wakacje będzie nawilżające brązujące masło do ciała z ekstraktem z orzecha i olejem z nasion marchwi. W ochronie skóry przeciw negatywnemu wpływowi chloru pomoże równiez Prebiotyczny krem emolientowy do skóry suchej i wrażliwej. Warto jednak pamiętać, że wszystko zależy od kondycji skóry i nie da się całkowicie wykluczyć skutków działania chloru - zwłaszcza dla skóry wrażliwej.
Noś ochronę
Stosowanie specjalnych kosmetyków ochronnych przed wejściem do basenu oraz okularków do pływania może chronić skórę i oczy przed bezpośrednim kontaktem z chlorowaną wodą. Kosmetyki te tworzą barierę ochronną, która ogranicza przenikanie chloru do skóry. Dodatkowo używanie ochronnych kremów z filtrem UV może dodatkowo chronić skórę przed szkodliwymi promieniami słonecznymi podczas kąpieli na otwartych basenach.
Zadbaj o jakość wody
Montaż filtrów w domowej instalacji wodnej może pomóc w redukcji ilości chloru w wodzie używanej do kąpieli i mycia. Filtry te mogą usuwać nie tylko chlor, ale także inne potencjalnie szkodliwe substancje, które mogą przyczyniać się do podrażnień skóry. Dzięki temu każda kąpiel będzie bezpieczniejsza i mniej obciążająca dla Twojej skóry, co jest szczególnie ważne dla osób z wrażliwą skórą.
Bielenda Barrier Renew to linia kosmetyków, które odżywią, zregenerują i nawilżą skórę, świetnie sprawdzi się do cer odwodnionych i przesuszonych.
Pielęgnacja skóry po kąpieli w słonej lub chlorowanej wodzie
Pielęgnacja skóry po kąpieli w chlorowanej wodzie jest kluczowa, aby zapobiegać podrażnieniom i utrzymać zdrowy wygląd skóry. Oto kilka wskazówek, jak zadbać o skórę po kąpieli:
Nawilżanie po kąpieli
Chlor, podobnie jak sól może powodować wysuszenie skóry, dlatego ważne jest, aby po każdej kąpieli intensywnie ją nawilżać. Używaj balsamów i kremów nawilżających, które pomagają odbudować naturalną barierę ochronną skóry. Produkty takie jak Bielenda Professional Supremelab Barrier Renew są doskonałym wyborem. Regularne stosowanie nawilżających kosmetyków pozwoli Twojej skórze szybciej się regenerować i odzyskać zdrowy wygląd oraz miękkość.
Wzmacnianie mikrobiomu
Mikrobiom skóry odgrywa kluczową rolę w jej zdrowiu. Stosowanie probiotycznych kosmetyków może pomóc w utrzymaniu równowagi mikroflory skóry. Seria MICROBIOME PRO CARE oferuje produkty wzmacniające mikrobiom, które warto włączyć do codziennej pielęgnacji. Wzmocnienie mikrobiomu skóry przyczynia się do zwiększenia jej odporności na szkodliwe czynniki zewnętrzne oraz wspiera naturalne procesy regeneracyjne skóry, co jest szczególnie ważne po ekspozycji na chlor.
Łagodzenie podrażnień
Jeśli zauważysz podrażnienia lub zaczerwienienia, sięgnij po produkty zawierające składniki łagodzące, takie jak aloes, pantenol czy ekstrakt z rumianku. Takie składniki pomagają szybko złagodzić objawy uczulenia i przyspieszyć regenerację skóry. Dzięki ich właściwościom kojącym Twoja skóra szybciej odzyska komfort i zdrowy wygląd, a regularne stosowanie tych produktów pomoże zapobiegać nawrotom podrażnień.
Codzienna pielęgnacja
Regularne nawilżanie skóry jest kluczowe, aby utrzymać ją w dobrej kondycji. Stosuj balsamy i kremy nawilżające kilka razy dziennie, szczególnie po kąpieli. Produkty takie jak Bielenda COCTAIL są doskonałym wyborem na co dzień i na wakacje. Soczyste kompozycje owocowe zapewniają optymalne nawilżenie, dzięki czemu Twoja skóra będzie mniej podatna na podrażnienia i przesuszenie, a jej bariera ochronna będzie bardziej odporna na szkodliwe działanie chloru.
Linia Bielenda Coctail to kosmetyki oczyszczające i pielęgnujące, które są bogate w ekstrakty roślinne i prebiotyki. Odżywiają, wspomagają regenerację skóry i nawilżają.
Profilaktyka i leczenie w przypadku nadwrażliwości na chlor
Jeżeli podejrzewasz, że masz nadwrażliwość na chlor, warto skonsultować się z dermatologiem. Jak przebiega leczenie? W przypadku uczulenia na chlor leczenie polega głównie na unikaniu kontaktu z chlorowaną wodą i stosowaniu odpowiedniej pielęgnacji skóry. W razie konieczności lekarz może zalecić stosowanie leków antyhistaminowych lub kortykosteroidowych maści. Regularne wizyty u specjalisty i przestrzeganie zaleceń mogą znacząco poprawić stan Twojej skóry i zapobiec nawrotom objawów. Podczas kąpieli w basenie warto także nosić ochronne okulary pływackich i czepki, które zmniejszają kontakt chlorowanej wody z Twoją skórą i oczami, minimalizując ryzyko podrażnień. Pamiętaj także o odpowiedniej pielęgnacji skóry po kąpieli i na co dzień.
Alternatywne metody dezynfekcji wody
Nie wszystkie baseny używają chloru do dezynfekcji. Coraz popularniejsze stają się metody ozonowania i stosowanie lamp UV, które również skutecznie eliminują drobnoustroje bez konieczności stosowania drażniących substancji chemicznych. Ozonowanie, wykorzystujące ozon jako środek dezynfekcyjny, jest równie skuteczne jak chlor, ale nie wywołuje podrażnień skóry ani dróg oddechowych. Lampy UV z kolei niszczą mikroorganizmy poprzez ekspozycję na promieniowanie ultrafioletowe, co jest bezpieczne dla skóry i oczu użytkowników basenu. Wybór takich basenów może być dobrą alternatywą dla osób z nadwrażliwością na chlor, szczególnie tych z atopowym zapaleniem skóry.
Wpływ chloru na zdrowie
Chlor, pomimo swoich właściwości dezynfekcyjnych, może mieć negatywny wpływ na zdrowie niektórych osób. Poza podrażnieniami skórnymi, długotrwałe narażenie na wysokie stężenia chloru może prowadzić do problemów z układem oddechowym, takich jak kaszel, świszczący oddech, a nawet astma. Wdychanie oparów chloru może powodować bóle głowy i zawroty głowy. Ponadto chlor może wpływać na stan błon śluzowych, prowadząc do ich wysuszenia i podrażnienia.
Podsumowanie
Chociaż chlorowanie wody basenowej jest skutecznym środkiem dezynfekcyjnym, może ono wywoływać różne reakcje uczuleniowe i podrażnienia skóry. Jeżeli masz nadwrażliwość na chlor, unikaj długiego kontaktu z chlorowaną wodą, stosuj odpowiednią pielęgnację skóry i rozważ korzystanie z basenów stosujących alternatywne metody dezynfekcji. Dzięki odpowiednim środkom ostrożności możesz cieszyć się pływaniem bez ryzyka dla zdrowia skóry. Stosując produkty pielęgnacyjne oferowane przez Bielenda, zapewnisz swojej skórze kompleksową ochronę i pielęgnację oraz wzmocnisz jej mikrobiom.